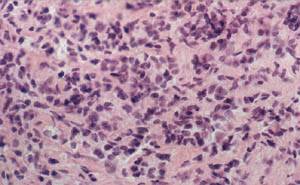

Брахитерапия в лечении рака предстательной железы
n-rколичество больных по каждой группе жалоб всего больных 3180
Из приведенной таблицы видно , что симптомы обструкции мочевого пузыря при раке предстательной железы встречаются довольно часто. Это связано с тем, что основной контингент больных встречается в возрасте за 60 лет и нередко у них имеется сопутствующая доброкачественная гиперплазия предстательной железы. Выраженность симптомов обструкции (вялая струя, затрудненное мочеиспускание и т.д.) напрямую связана со степенью сдавления опухолью мочеиспускательного канала. Сама по себе обструкция мочевого пузыря может вызвать и сопутствующую симптоматику - повторяющиеся воспаления мочевых путей, которые могут проявляться также болезненным частым мочеиспусканием. В зависимости от величины сдавления может возникнуть хроническая задержка мочи. Чем больше сдавление, тем выраженее симптомы обструкции.
Симптомы раздражения мочевых путей (учащенное мочеиспускание, невозможность сдержать мочеиспускание), возникают в результате нестабильности самого детрузора в результате обструкции. Все описанные симптомы могут быть вызваны вовлечением в опухолевый процесс тазовых нервов и мочеиспускательного треугольника.
Симптомы ограниченного и местно-распространенного РПЖ.
Симптомы обструкции мочевыводящих путей, как было отмечено выше, встречаются довольно часто и обычно сопровождаются рядом других проявлений болезни. Так, при прорастании опухолью простатической части уретры возникает гематурия и болезненное мочеиспускание. В том же случае, если в опухолевый процесс вовлекается сфинктер мочеиспускательного канала, развивается недержание мочи. В подобной ситуации врачу необходимо дифференцировать недержание мочи из-за хронической задержки и переполнения мочевого пузыря с опухолевым поражением сфинктера. При хронической задержке все симптомы возможно устранить при помощи трансуретральной резекции предстательной железы
Прорастание опухоли в окружающие ткани может вовлечь и сосудисто-нервный пучок, проходящий вдоль боковой поверхности простаты, что в свою очередь может сказаться на потенции больного. Вовлечение в опухолевый процесс промежуточного или надлобкового нерва чаще всего вызывает боли в промежности. Этот возможный вариант возникновения болей необходимо учитывать, когда речь идет о подозрении на простатит.
Местно-распространенный рак предстательной железы может прорасти в дистальный отдел прямой кишки и сдавить её просвет. В подобных случаях заболевание будет проявляться запорами, тенезмами кровотечениями, выделением слизи из прямой кишки; возможна клиника толстокишечной непроходимости.
Диссеминированный рак предстательной железы.
Появление отдаленных метастазов рака предстательной железы меняет и клиническое проявление болезни.
В странах СНГ до 70% больных раком предстательной железы обращаются к врачу уже в 3-4 стадии заболевания, при наличии метастазов. Основной симптом, который заставляет больного обращаться к врачу - это боли, которые появляются при метастазах в кости. Локализация болей обычно соответствует локализации метастазов, за исключением конечностей, где боли, могут быть проводниковыми из-за сдавления нервных корешков при метастатическом поражении позвоночника. Боли имеют тенденцию постепенно усиливаться. Особенно резкие боли возникают при патологических переломах, например шейки бедра. Метастазы в позвоночнике могут привести к сдавлению спинного мозга, что в свою очередь может вызвать параплегию.
У некоторых больных клинические проявления заболевания определяются метастазами в лимфатические узлы. На первых порах увеличиваются запирательные и внутренние подвздошные лимфатические узлы, которые по мере роста опухоли вовлекают в процесс окружающие органы и ткани - уретру, мочевой пузырь, мочеточники. Соответственно и клиническое проявление болезни определяется степенью вовлечения перечисленных органов в опухолевое поражение. Например, сдавление или прорастание мочеточников, может вызвать обструкцию мочеточников, что в свою очередь может привести к анурии. Диссеминация опухоли может привести к поражению практически любой группы лимфатических узлов: шейных, паховых, надключичных, подвздошных и т.д. Состояние больного постепенно ухудшается, наступает кахексия, дизурия, кровотечения. В начальных стадиях рак предстательной железы практически клинически не проявляется, и его выявляют обычно случайно(у 5-10 % мужчин), после операции по поводу доброкачественной гиперплазии простаты( трансуретральной резекции простаты, чреспузырной аденомэктомии).
Патологоанатомическая классификация.
Криброзная аденокарцинома предстательной железы.
![]() |
Недифферинцированный рак предстательной железы
![]() |
![]() |
Мелкоационотическия карцинома предстательной железы
Диагностика РПЖ
С целью выявления рака предстательной железы принято проводить три необходимых исследования:
I. Пальцевое исследование простаты.
II.Определение уровня простато-специфического антигена (ПСА).
III.Ультразвуковое исследование (УЗИ) простаты, при показаниях - одновременно с биопсией.
Пальцевое исследование прямой кишки.
В результате пальпации врач может выявить следующие симптомы опухоли предстательной железы:
Асимметричная предстательная железа. Плотной или деревянистой консистенции части предстательной железы. Плотность может определяться в виде отдельных узлов, либо различной величины инфильтратов, вплоть до перехода их на стенки таза. Неподвижность железы вследствие сращения её с окружающими тканями.
Данные, полученные при пальпации, не всегда легко интерпретировать, так как ложно - положительный диагноз рака предстательной железы возможно поставить при других заболеваниях:
· Доброкачественная гиперплазия предстательной железы
· Камни предстательной железы .
· Простатит.
· Флеболиты стенки прямой кишки
· Полипы или рак прямой кишки.
· Аномалии семенных пузырьков.
Результаты пальпации безусловно очень трудно дифференцировать от перечисленных заболеваний, но зато они являются вескими основаниями для дальнейшего обследования больного. В среднем только у одной трети случаев пальпируемых узлов предстательной железы впоследствии гистологически верифицируют рак простаты.
![]() |